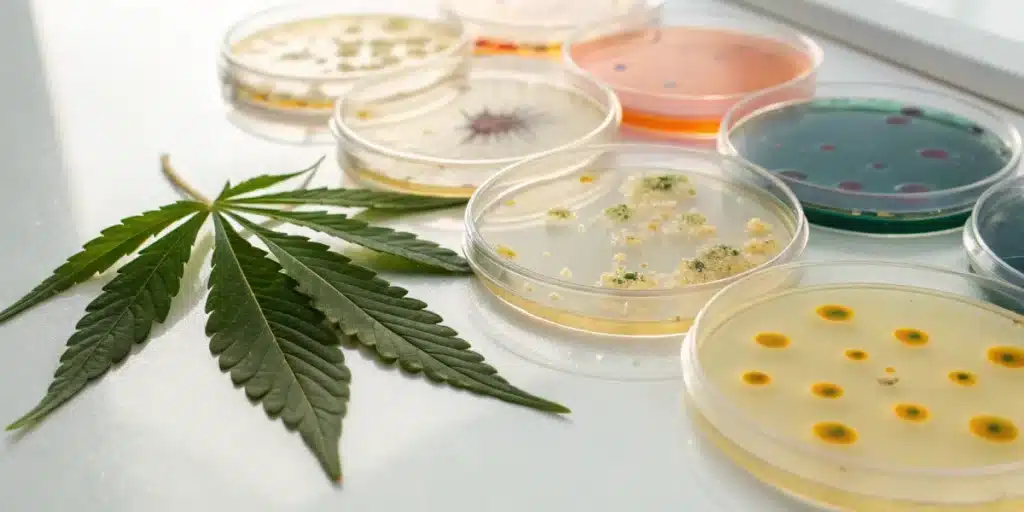
Realistic close-up of lab tests for microbes and bacteria in cannabis showing culture plates and sample.

How to Test for Microbes and Bacteria in Cannabis
What Are Microbes and Bacteria in Cannabis?
When it comes to cannabis cultivation, the world of microbes and bacteria can be both fascinating and daunting. Microbes encompass a wide range of microscopic organisms, including bacteria, fungi, and viruses. While some of these organisms are harmful and can wreak havoc on your plants, many others play a vital role in promoting healthy growth. In the cannabis ecosystem, beneficial microbes can improve nutrient uptake, enhance soil structure, and even protect plants from pathogens.
Realizing the types of microbes and bacteria present in your cannabis plants is essential for successful cultivation. For instance, some bacteria, like Rhizobium, are known for their nitrogen-fixing capabilities, while mycorrhizal fungi can assist roots in absorbing water and nutrients. However, it’s essential to maintain a balance; an overabundance of harmful microbes can result in diseases such as root rot, powdery mildew, and more.
Recommended Strains
Head Band
| | THC | 18% - 24% (Medium) |
| | Type | Feminized |
| | Yield | Medium |
| | Phenotype | 50% Indica / 50% Sativa |
Blue Head Band Auto
| | THC | 18% - 24% (Medium) |
| | Type | Autoflowering |
| | Yield | High |
| | Phenotype | 50% Indica / 50% Sativa |
Why Testing Is Essential
Testing for microbes and bacteria in cannabis is not just a precaution; it’s an integral part of maintaining a healthy grow. By regularly assessing the microbial population, cultivators can identify potential problems before they escalate. A proactive approach allows growers to implement corrective measures, ensuring their plants remain in peak health.
Moreover, microbial testing helps in understanding the overall health of your growing environment. Healthy soil teeming with beneficial microbes can lead to stronger, more resilient plants, which in turn can yield higher quality buds. With testing, you can establish a baseline and monitor changes over time, making adjustments to your cultivation practices as necessary.
Promos & Deals
Methods for Testing Microbes and Bacteria
Laboratory Testing Techniques
Laboratory testing is one of the most reliable methods for evaluating microbial populations in cannabis. This technique typically involves sending samples to a certified lab, where professionals use advanced equipment to analyze the microbial content. The testing can identify specific types of bacteria and fungi present, along with their concentrations. Many labs offer comprehensive reports that include recommendations for addressing any issues found.
One common laboratory technique is culturing, where samples are placed on selective media that encourages the growth of certain microbes while inhibiting others. After incubation, colonies are counted and identified. This method can provide insights into harmful pathogens as well as beneficial species, giving growers a clear picture of their microbial landscape.
On-Site Testing Procedures
For those seeking immediate results, on-site testing kits can be an excellent alternative to laboratory methods. These kits are user-friendly and often come with detailed instructions, making them accessible even for novice growers. They allow you to collect samples from your plants or growing medium and conduct tests right in your grow room.
On-site tests typically use colorimetric assays or PCR (Polymerase Chain Reaction) methods to detect microbial DNA. While they may not provide as comprehensive data as laboratory tests, they can quickly indicate whether harmful microbes are present. This immediacy can be invaluable when time is of the essence, allowing growers to take action without delay.

How to Test for Microbes and Bacteria in Cannabis: Interpreting Test Results
What the Results Reveal
Once you receive your test results, the next step is interpreting what they mean for your cannabis plants. Understanding the data can help you make informed decisions about your growing practices. High levels of harmful bacteria, for instance, may signal an impending issue that could lead to plant stress or disease.
On the other hand, a rich diversity of beneficial microbes suggests that your growing conditions are favorable. Balancing these populations is key; too many harmful microbes can outcompete beneficial ones, leading to a decline in plant health. Each test result can provide valuable insights, guiding you toward the best practices for your unique growing environment.
Actions Based on Test Outcomes
After interpreting your test results, it’s time to take action. If harmful microbes are detected, immediate remediation is crucial. This might involve adjusting your watering practices, improving airflow, or even applying specific treatments to eliminate pathogenic organisms. Conversely, if beneficial microbes are thriving, consider ways to enhance their numbers further, such as incorporating organic amendments or implementing crop rotation.
Remember that growing cannabis is a dynamic process. Regular testing and subsequent adjustments create a feedback loop that helps ensure a healthy growing environment. By staying proactive, you can maintain a flourishing garden that yields high-quality cannabis.
Enhancing Microbial Health in Your Grow
Organic Practices to Support Beneficial Microbes
One of the best strategies for promoting beneficial microbes is to adopt organic practices in your cultivation. Organic fertilizers, compost, and microbial inoculants can enrich your soil, providing a hospitable environment for beneficial organisms to thrive. These practices not only support microbial health but also improve soil structure and water retention, creating a more resilient growing medium.
Additionally, avoiding synthetic chemicals and pesticides can help maintain a balanced microbial ecosystem. While these products may provide short-term benefits, they can disrupt the delicate balance of beneficial microbes, leading to long-term issues. Instead, consider utilizing organic pest control methods and natural amendments to support your plants without sacrificing microbial health.
Adjusting Cultivation Based on Test Feedback
As you receive ongoing feedback from microbial testing, it’s essential to adapt your cultivation practices accordingly. For instance, if your tests indicate a high level of pathogenic bacteria, you might need to alter your watering schedule to prevent over-saturation, which can encourage disease. Conversely, if beneficial microbes are lacking, consider adjusting your nutrient strategy to support their growth.
This ongoing process of testing and adapting is critical for achieving optimal plant health and maximizing yields. Each grow cycle is an opportunity to learn and improve, leading to a more successful and sustainable cultivation experience.
FAQs about How to Test for Microbes and Bacteria in Cannabis
What tests are available for detecting microbes and bacteria?
Various tests are available, including laboratory culturing methods and on-site testing kits. Laboratory tests typically provide more detailed insights into microbial populations, while on-site kits offer quicker results for immediate concerns.
How reliable are these testing methods?
The reliability of testing methods can vary. Laboratory tests are generally considered more accurate due to advanced techniques and equipment, while on-site kits can provide useful preliminary data but may lack the detail of lab results.
Can these tests be performed at home?
Yes, many on-site testing kits are designed for home use and can be performed easily by growers. However, for comprehensive analysis and understanding, laboratory testing is recommended.














